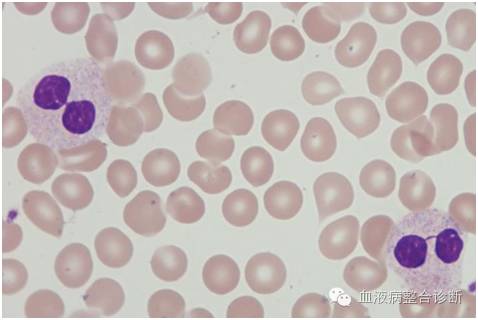
杜勒小体
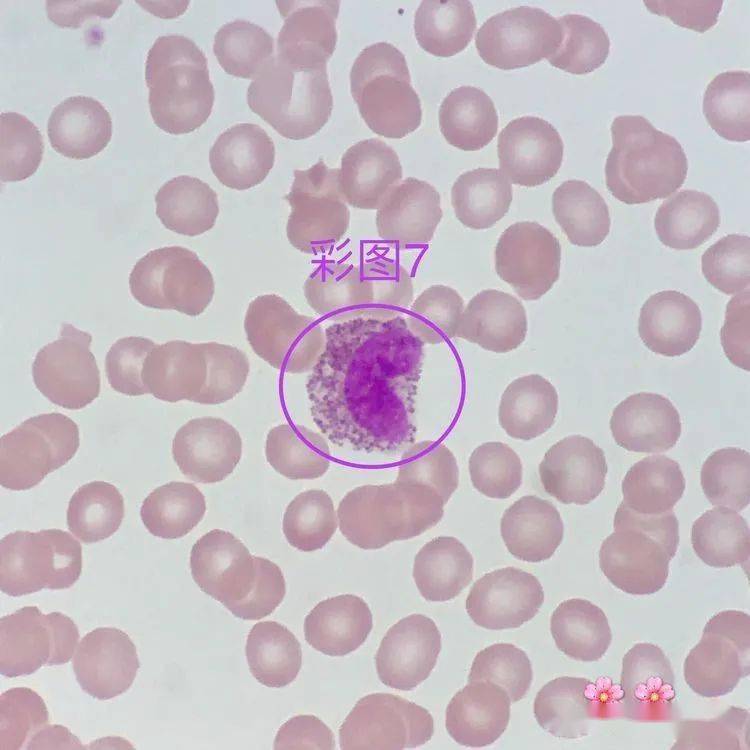
07形态特征:胞体圆形或类圆形;胞质较少,淡蓝色,可见少量细小颗粒

杜勒小体

杜勒小体⑤退行性变:表现为胞体肿大,结构模糊,边缘不清.
图片尺寸441x323
秀山医学检验质量控制中心第二十六期形态学培训答案解析
图片尺寸1065x1287
细胞中的这个小物体连检验科医生都会错过
图片尺寸1080x1235
细胞中的这个小物体连检验科医生都会错过
图片尺寸799x1730
肺ca wbc↑ hb↓ l↓表现中毒颗粒 杜勒小体 空泡# - 抖音
图片尺寸1440x2560
「含有杜勒氏小体的中性分叶核粒细胞」 形态特征:中性粒细胞因毒性
图片尺寸640x640
杜勒小体
图片尺寸478x320
儿童中性粒细胞百分比偏低是什么原因导致的
图片尺寸941x941
杜勒小体
图片尺寸268x179
杜勒小体
图片尺寸475x320
罕见的白细胞包涵体,遇见便此生铭记!_腾讯新闻
图片尺寸964x934
2018年细胞形态学培训考试
图片尺寸596x453
杜勒小体
图片尺寸481x321
07形态特征:胞体圆形或类圆形;胞质较少,淡蓝色,可见少量细小颗粒
图片尺寸750x750
杜勒小体
图片尺寸475x320
神经元及其神经纤维的基本病变 包涵体形成 parkinson病患者黑质神经
图片尺寸1080x810
20192019比较形态学毛峥嵘2班浙江大学最新满分章节测试答案
图片尺寸890x566
该图片采自间日疟原虫患者.「疟原虫成熟裂殖体」▼
图片尺寸750x750
前鞭毛体(promastigote)寄生于白蛉消化道.
图片尺寸394x286
尼氏小体
图片尺寸1080x810